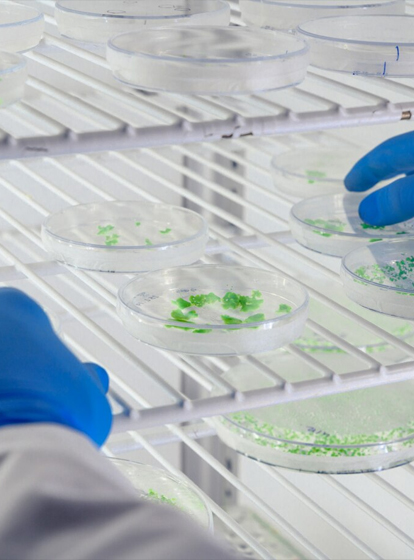

Personalizzazione mirata

Nella lavorazione della plastica, un controllo accurato della temperatura è essenziale per determinare la qualità del prodotto finale.
Qui alcuni esempi di applicazioni:
- Estrusori
- Macchine per lo stampaggio ad iniezione
- Macchine per lo stampaggio mediante soffiatura
- Macchine per il riciclaggio
- Attrezzature ausiliarie e accessori

Soluzioni per l’automazione industriale di:
- Forni per saldatura a rifusione
- Macchine saldatrici ad onda
- Macchine saldatrici ad onda selettiva
- Forni di polimerizzazione verticale
- Attrezzature per l'ispezione visiva AOI
- Attrezzature per l'ispezione visiva SPI

Soluzioni per l’automazione industriale di:
- Forni per la tempra del vetro
- Fornaci di omogenizzazione
- Attrezzature per il rivestimento

Qui alcuni esempi di applicazioni:
- Cucine / Forni di cottura
- Forni rotativi per pizza
- Forni e attrezzature per panifici
- Macchine per il caffe’
- Attrezzature per fast food
- Distributori automatici

Qui alcuni esempi di applicazioni:
- Apparecchiature fotovoltaiche
- Attrezzature per la produzione di batterie agli ioni di litio
- Dispositivi di accumulo dell'energia
- Auto elettriche
- Pile di carica
- Energia eolica e pompe di calore geotermiche

Qui alcuni esempi di applicazioni:
- Lettini per ospedali
- Macchinari per dialisi
- Incubatrici neonatali/Apparecchi per la gestione della temperatura del paziente
- Refrigeratori medici
- Macchinari per la sterilizzazione da laboratorio
- Analizzatori del sangue/Centrifughe
- Poltrone odontoiatriche

Qui alcuni esempi di applicazioni:
- Macchine riempitrici
- Macchine per chiudere/sigillare
- Macchine per termoformatura
- Tunnel per termoretrazione
- Macchine avvolgitrici e fardellatrici
- Macchine per soffiaggio PET
- Macchine Etichettatrici

Qui alcuni esempi di applicazioni:
- HVAC(Sistemi di riscaldamento, ventilazione e aria condizionata)
- Sistemi di riscaldamento a pavimento ad alta tensione
- Compressori per frenatura idraulica o pneumatica
- Compressori per lubrificazione ruote
- Riscaldatori per scambi ferroviari
- Segnaletica ferroviaria

Qui alcuni esempi di applicazioni:
- Ascensori per passeggeri
- Ascensori per abitazioni
- Ascensori panoramici
- Ascensori merci
- Ascensori per autovetture
- Scale mobili
Qui alcuni esempi di applicazioni:
- Camere ad alta e bassa temperatura
- Camere a temperatura e umidita’ costanti
- Camere per invecchiamento UV

Qui alcuni esempi di applicazioni:
- Piloni missilistici

Qui alcuni esempi di applicazioni:
- Telecamere di sorveglianza